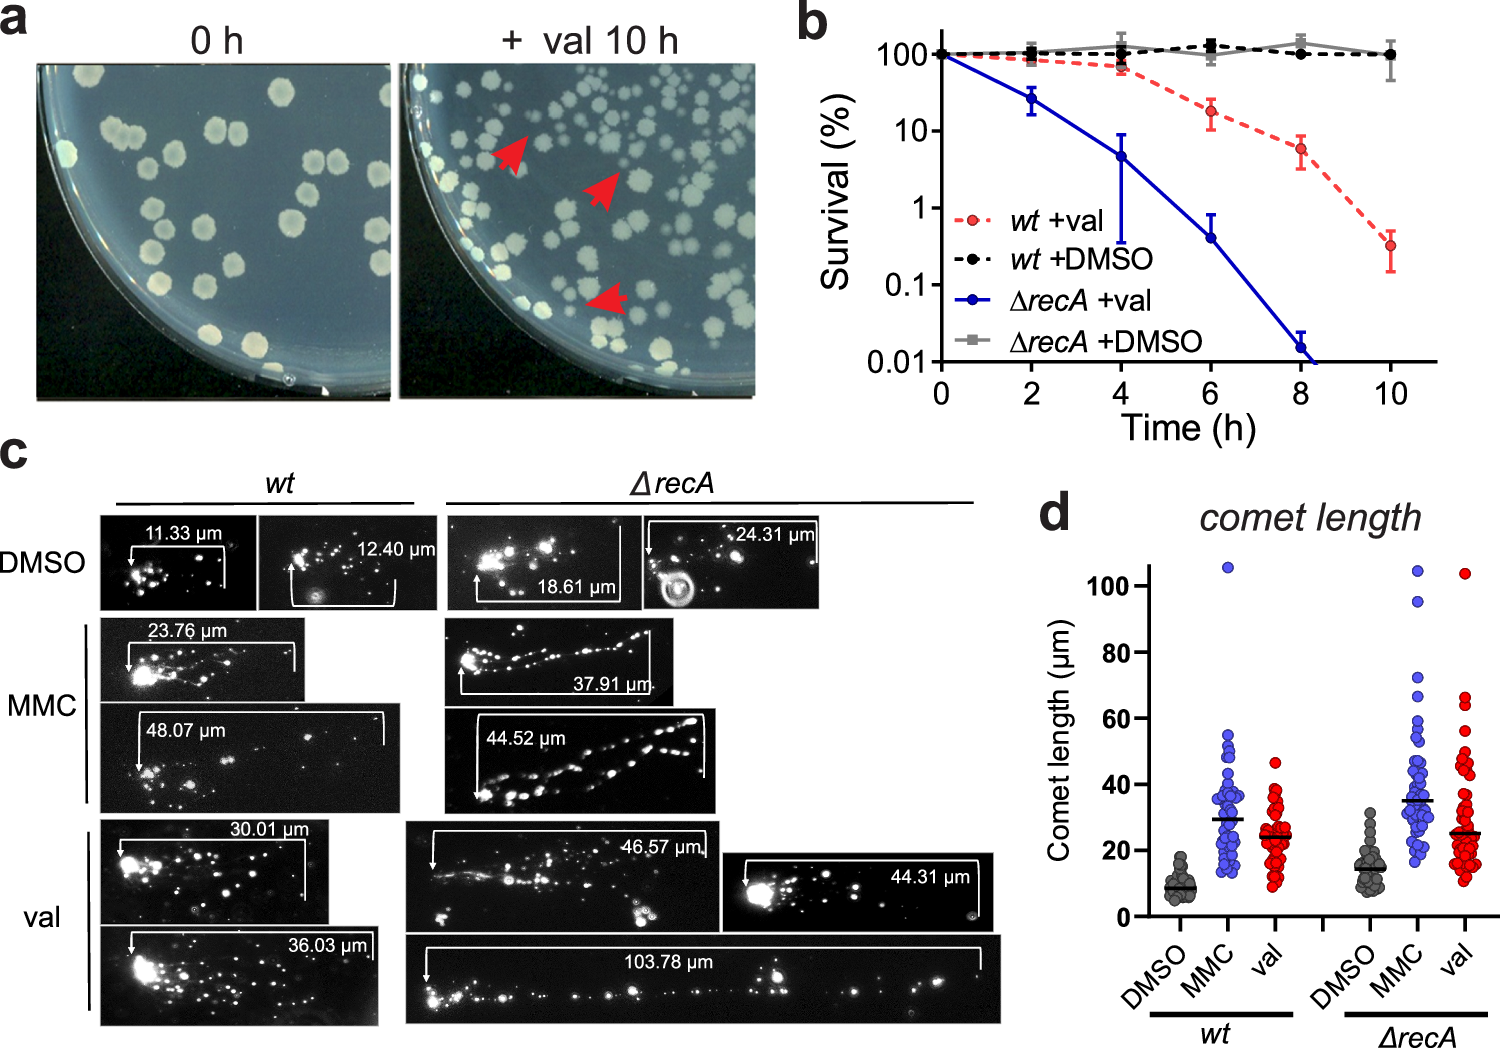
Fig. 2

Fig. 2: Possible cause of killing upon membrane potential dissipation.
From: Membrane depolarization kills dormant Bacillus subtilis cells by generating a lethal dose of ROS
a Colonies of stationary phase cells treated with valinomycin for 0 h and 10 h. Some small colonies are indicated by red arrows. b Survival curves of a recA deletion strain (ΔrecA). 100 µM valinomycin was used and 1 % DMSO as negative control. wt indicates wild type cells. The data shown reflect the mean ± SD of three biological replicates. c DNA damage assessment using a comet assay. Wild type (wt) and ΔrecA cells were treated 2 h with either 100 µM valinomycin (val) or 50 ng/ml of the DNA damaging agent mitomycin C (MMC). Control cells were treated with 1 % DMSO for 2 h. Cells were lysed and electrophoresed on microscopy slides, and nucleoids were visualized using fluorescence light microscopy. Increased DNA breakage results in more stretched DNA. d Quantification of the DNA comet lengths of 50 cells.
